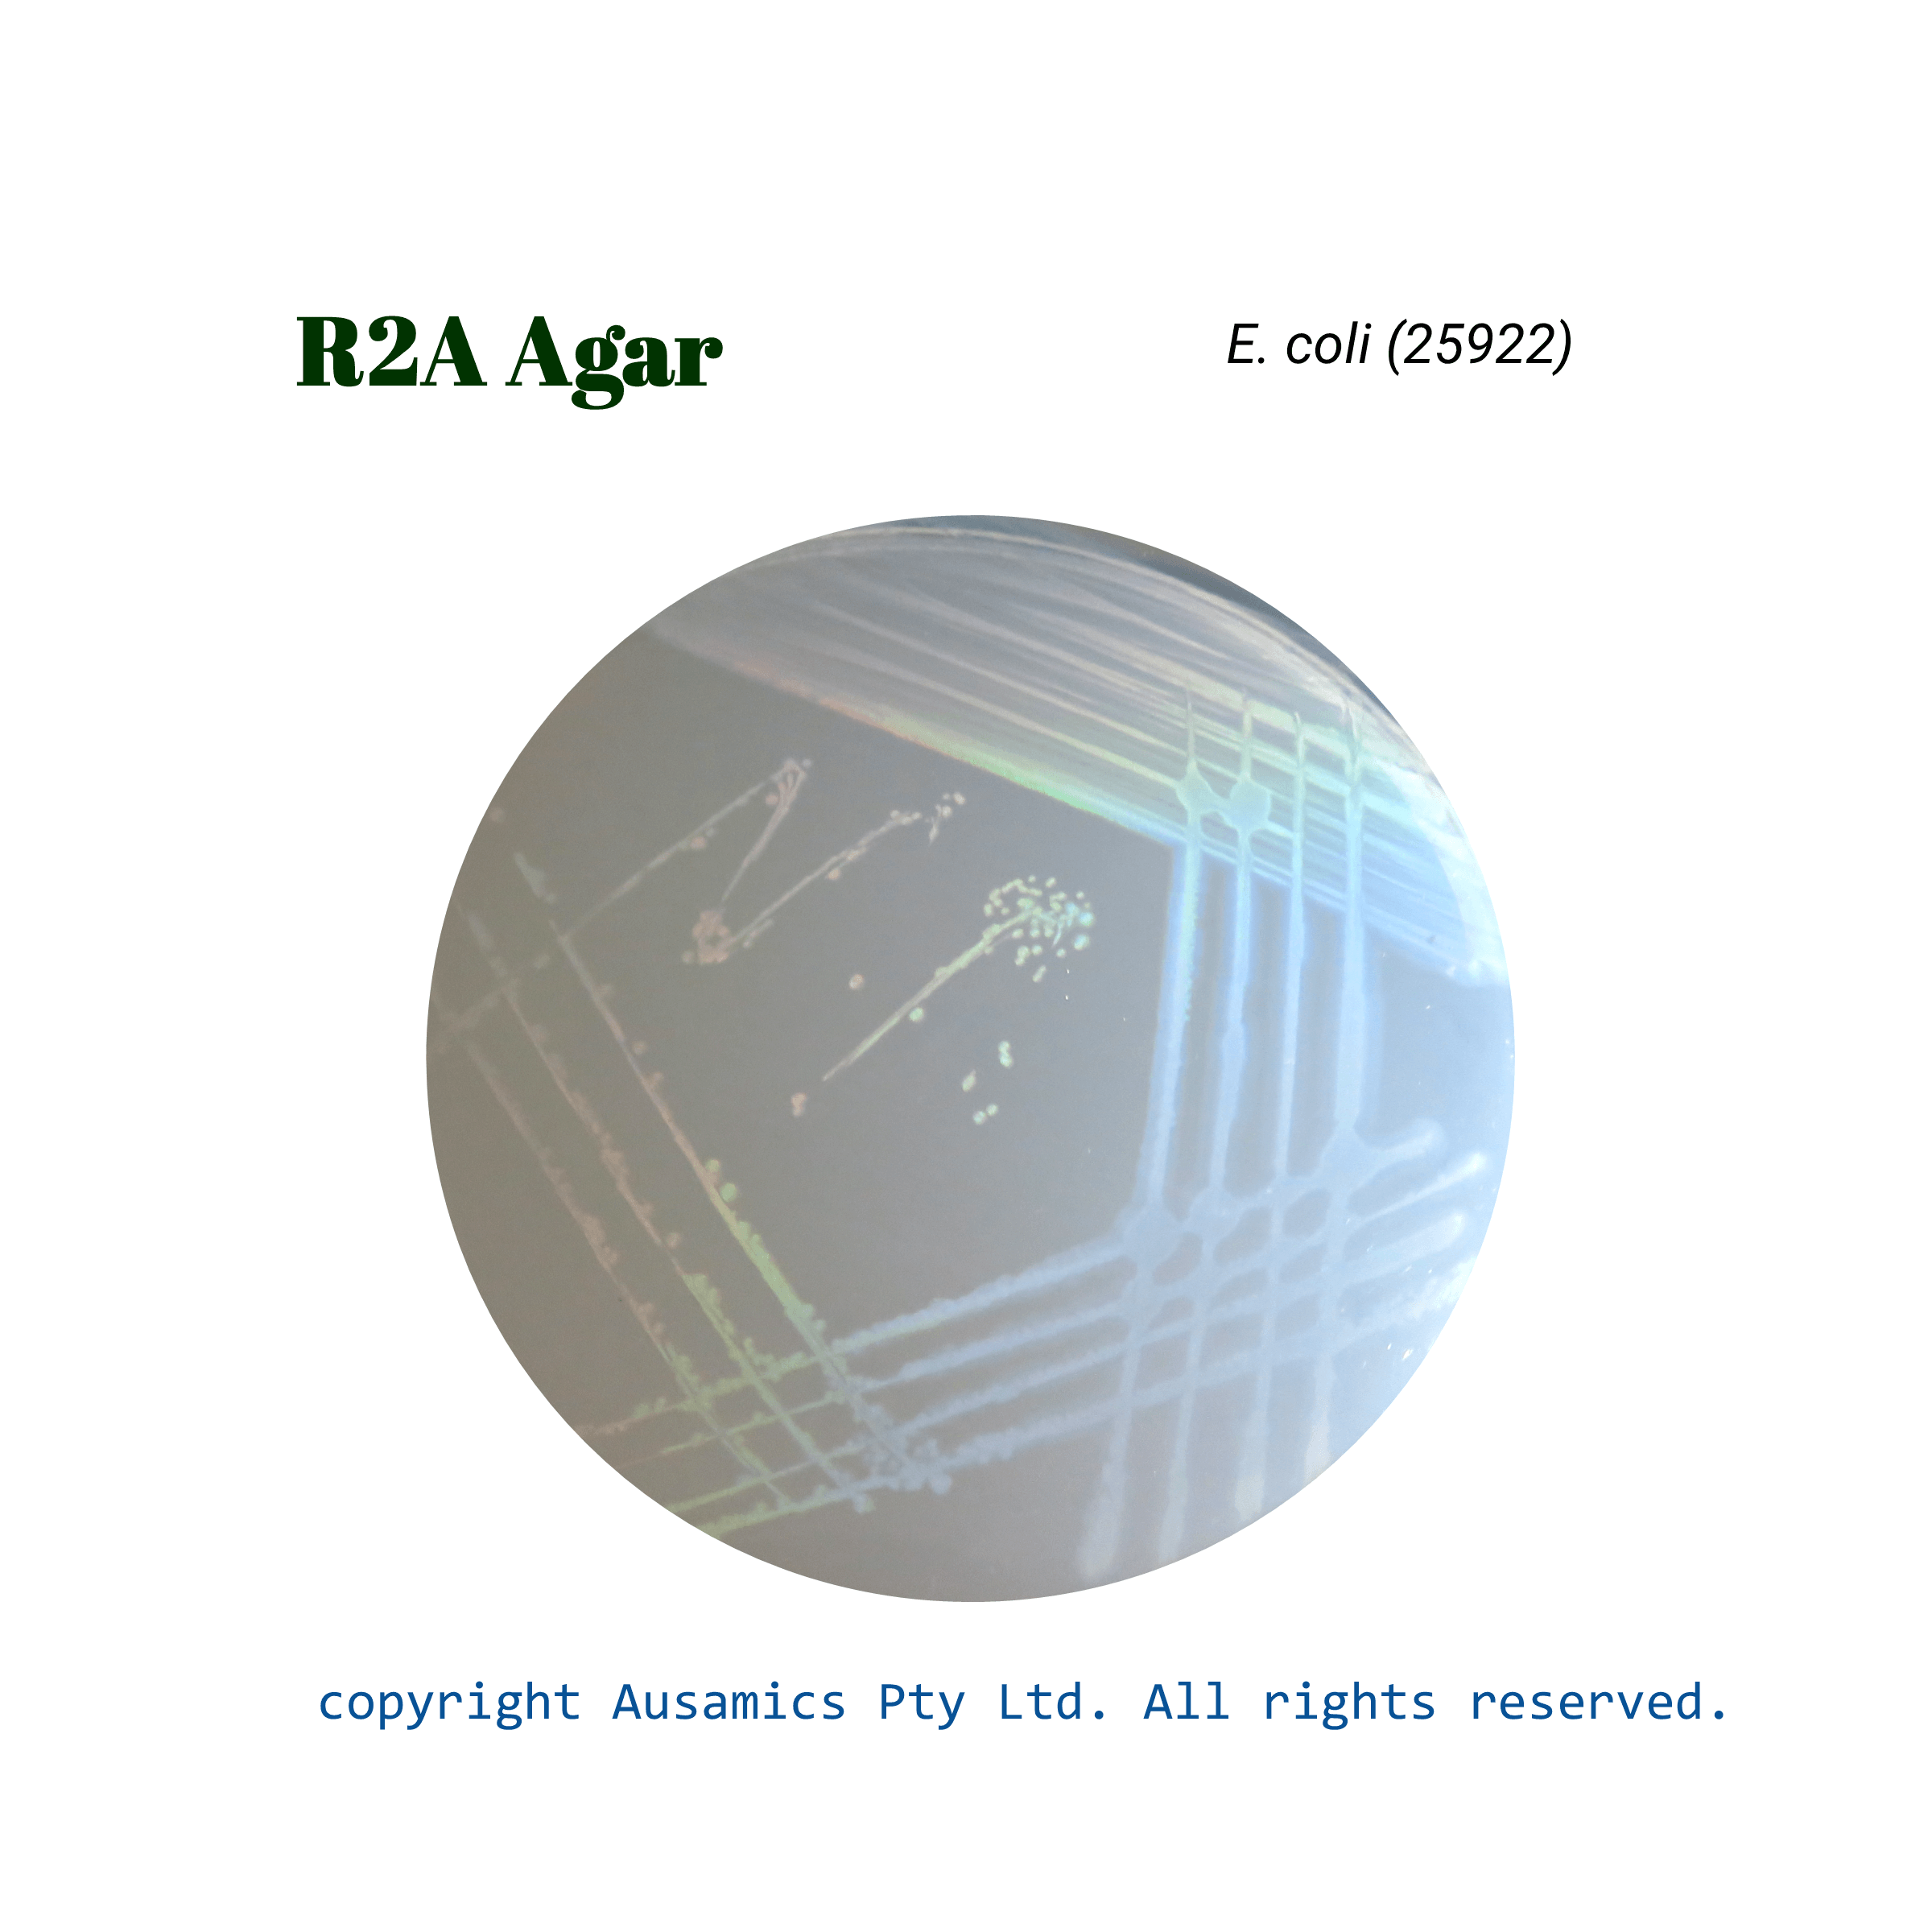
R2A_Agar_Ecoli(25922)_Ausamics
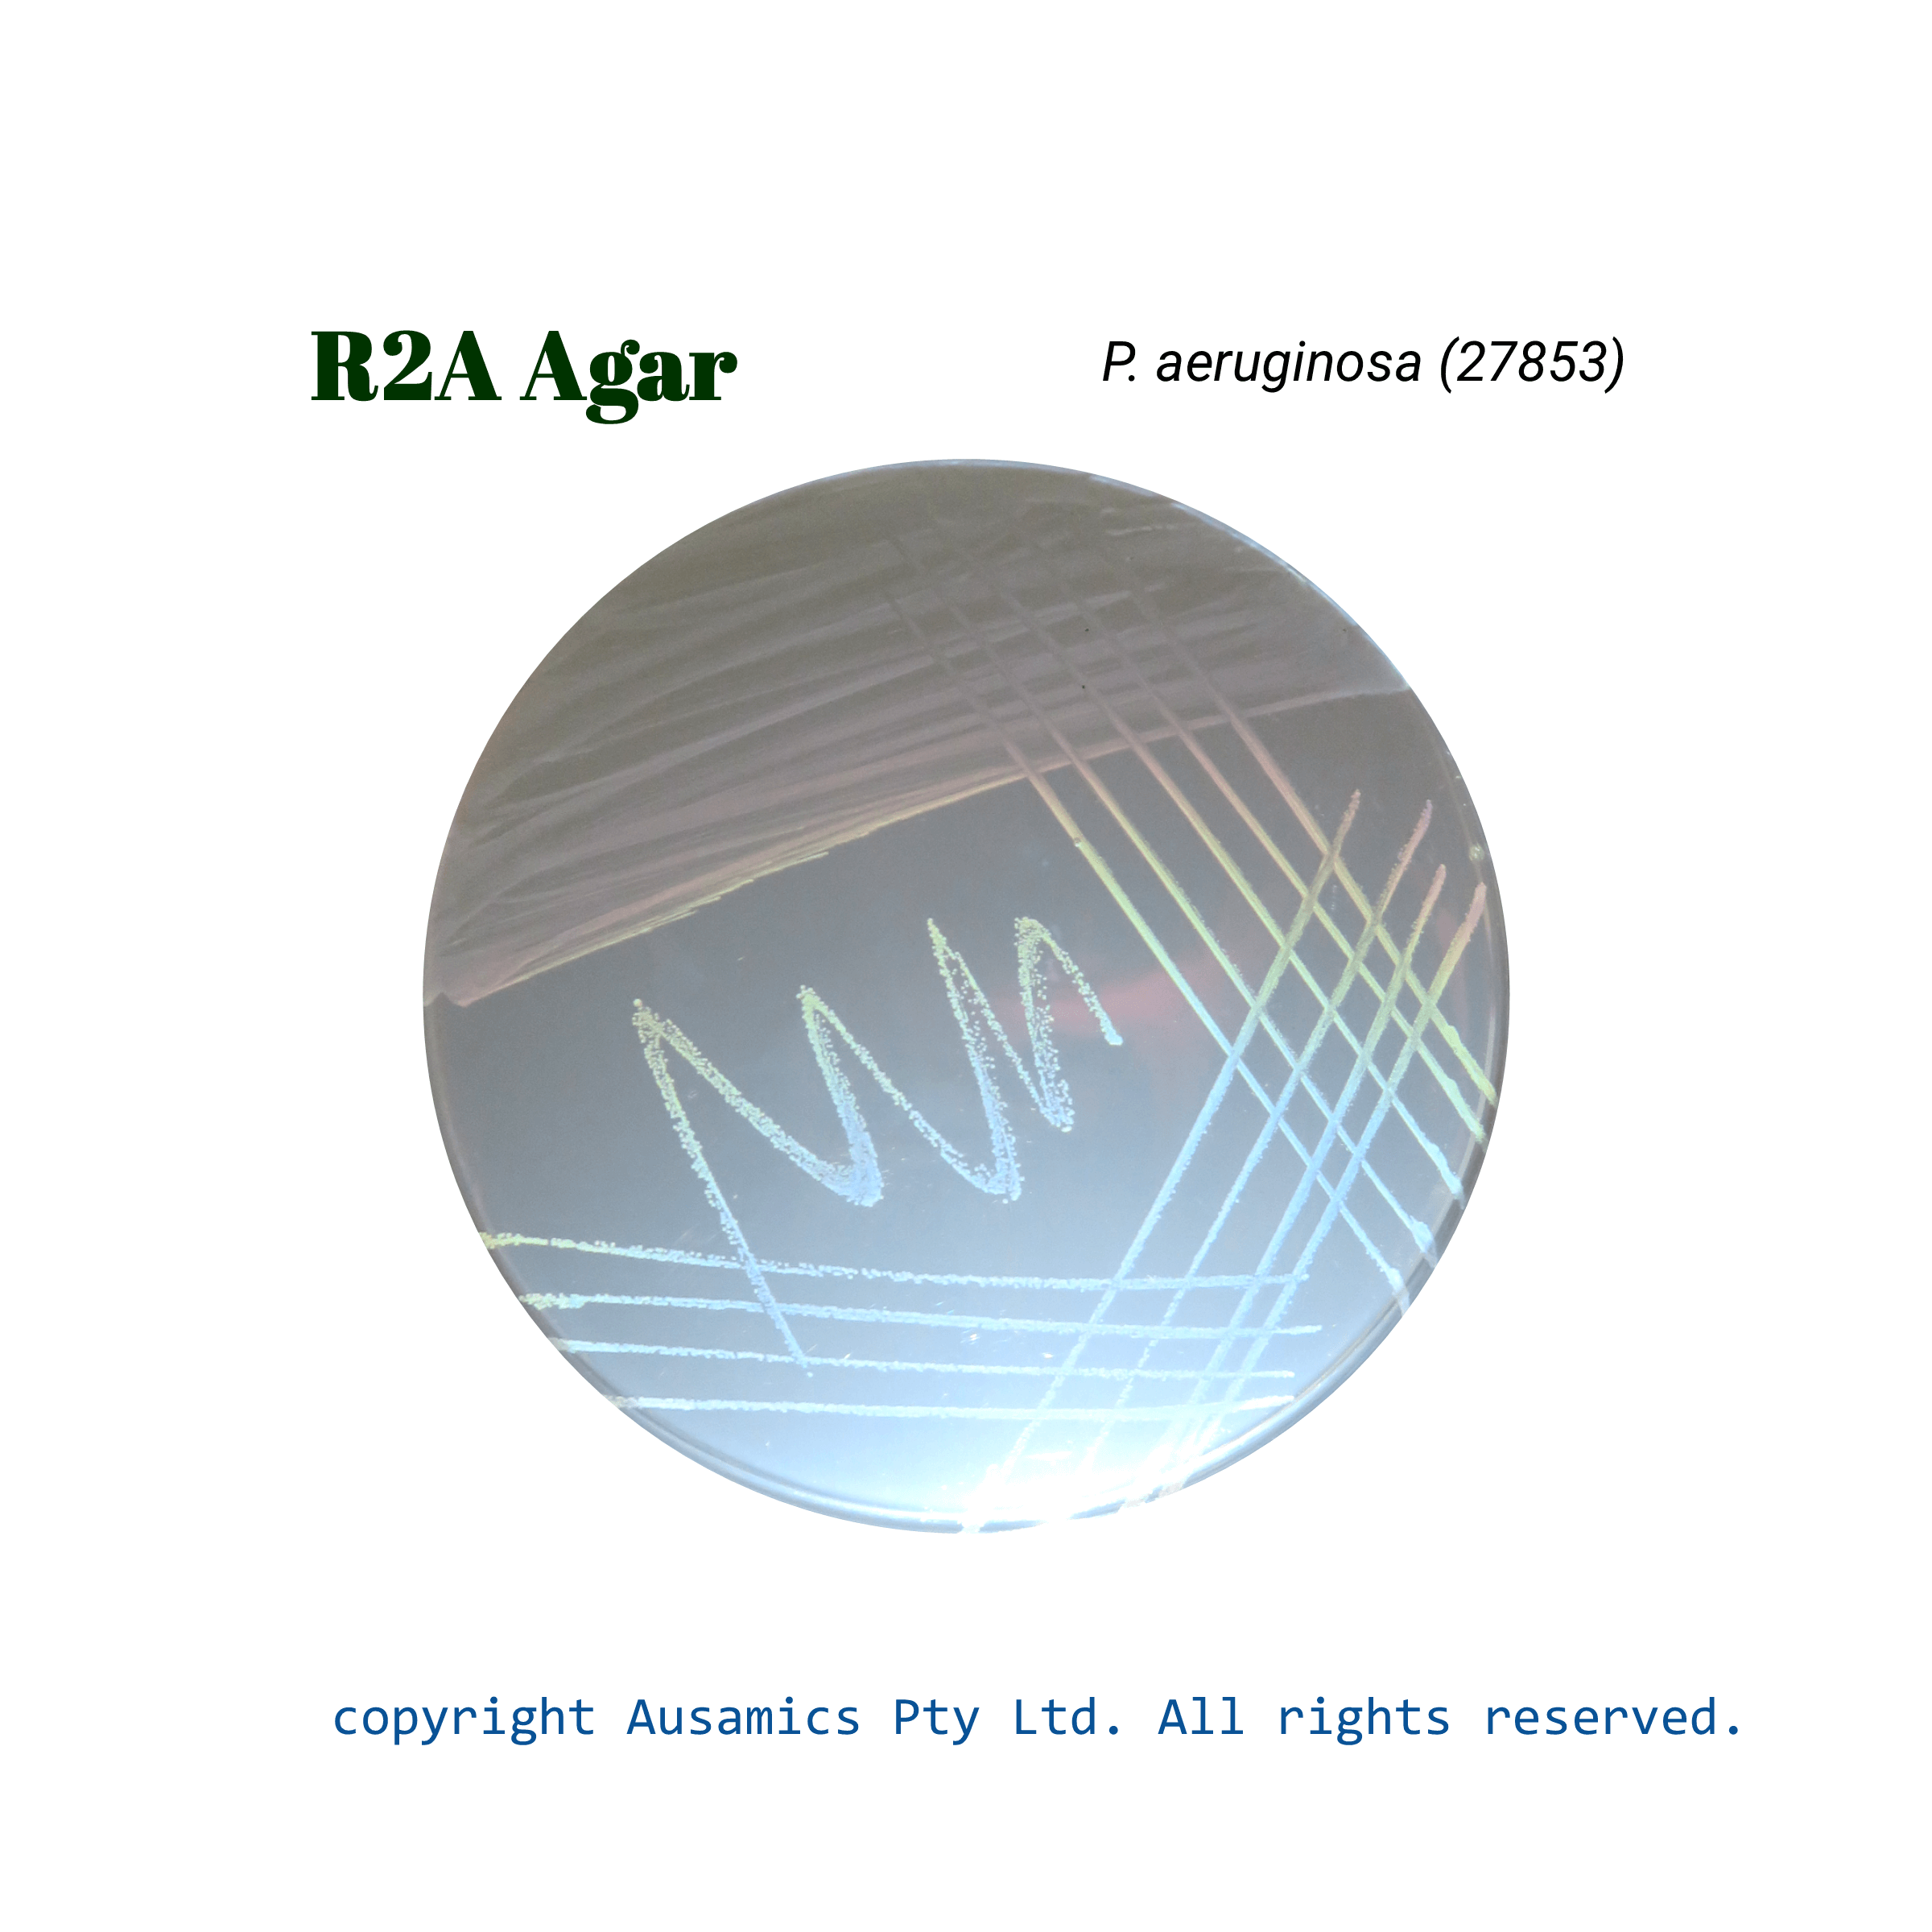
R2A_Agar_Paeruginosa(27853)_Ausamics
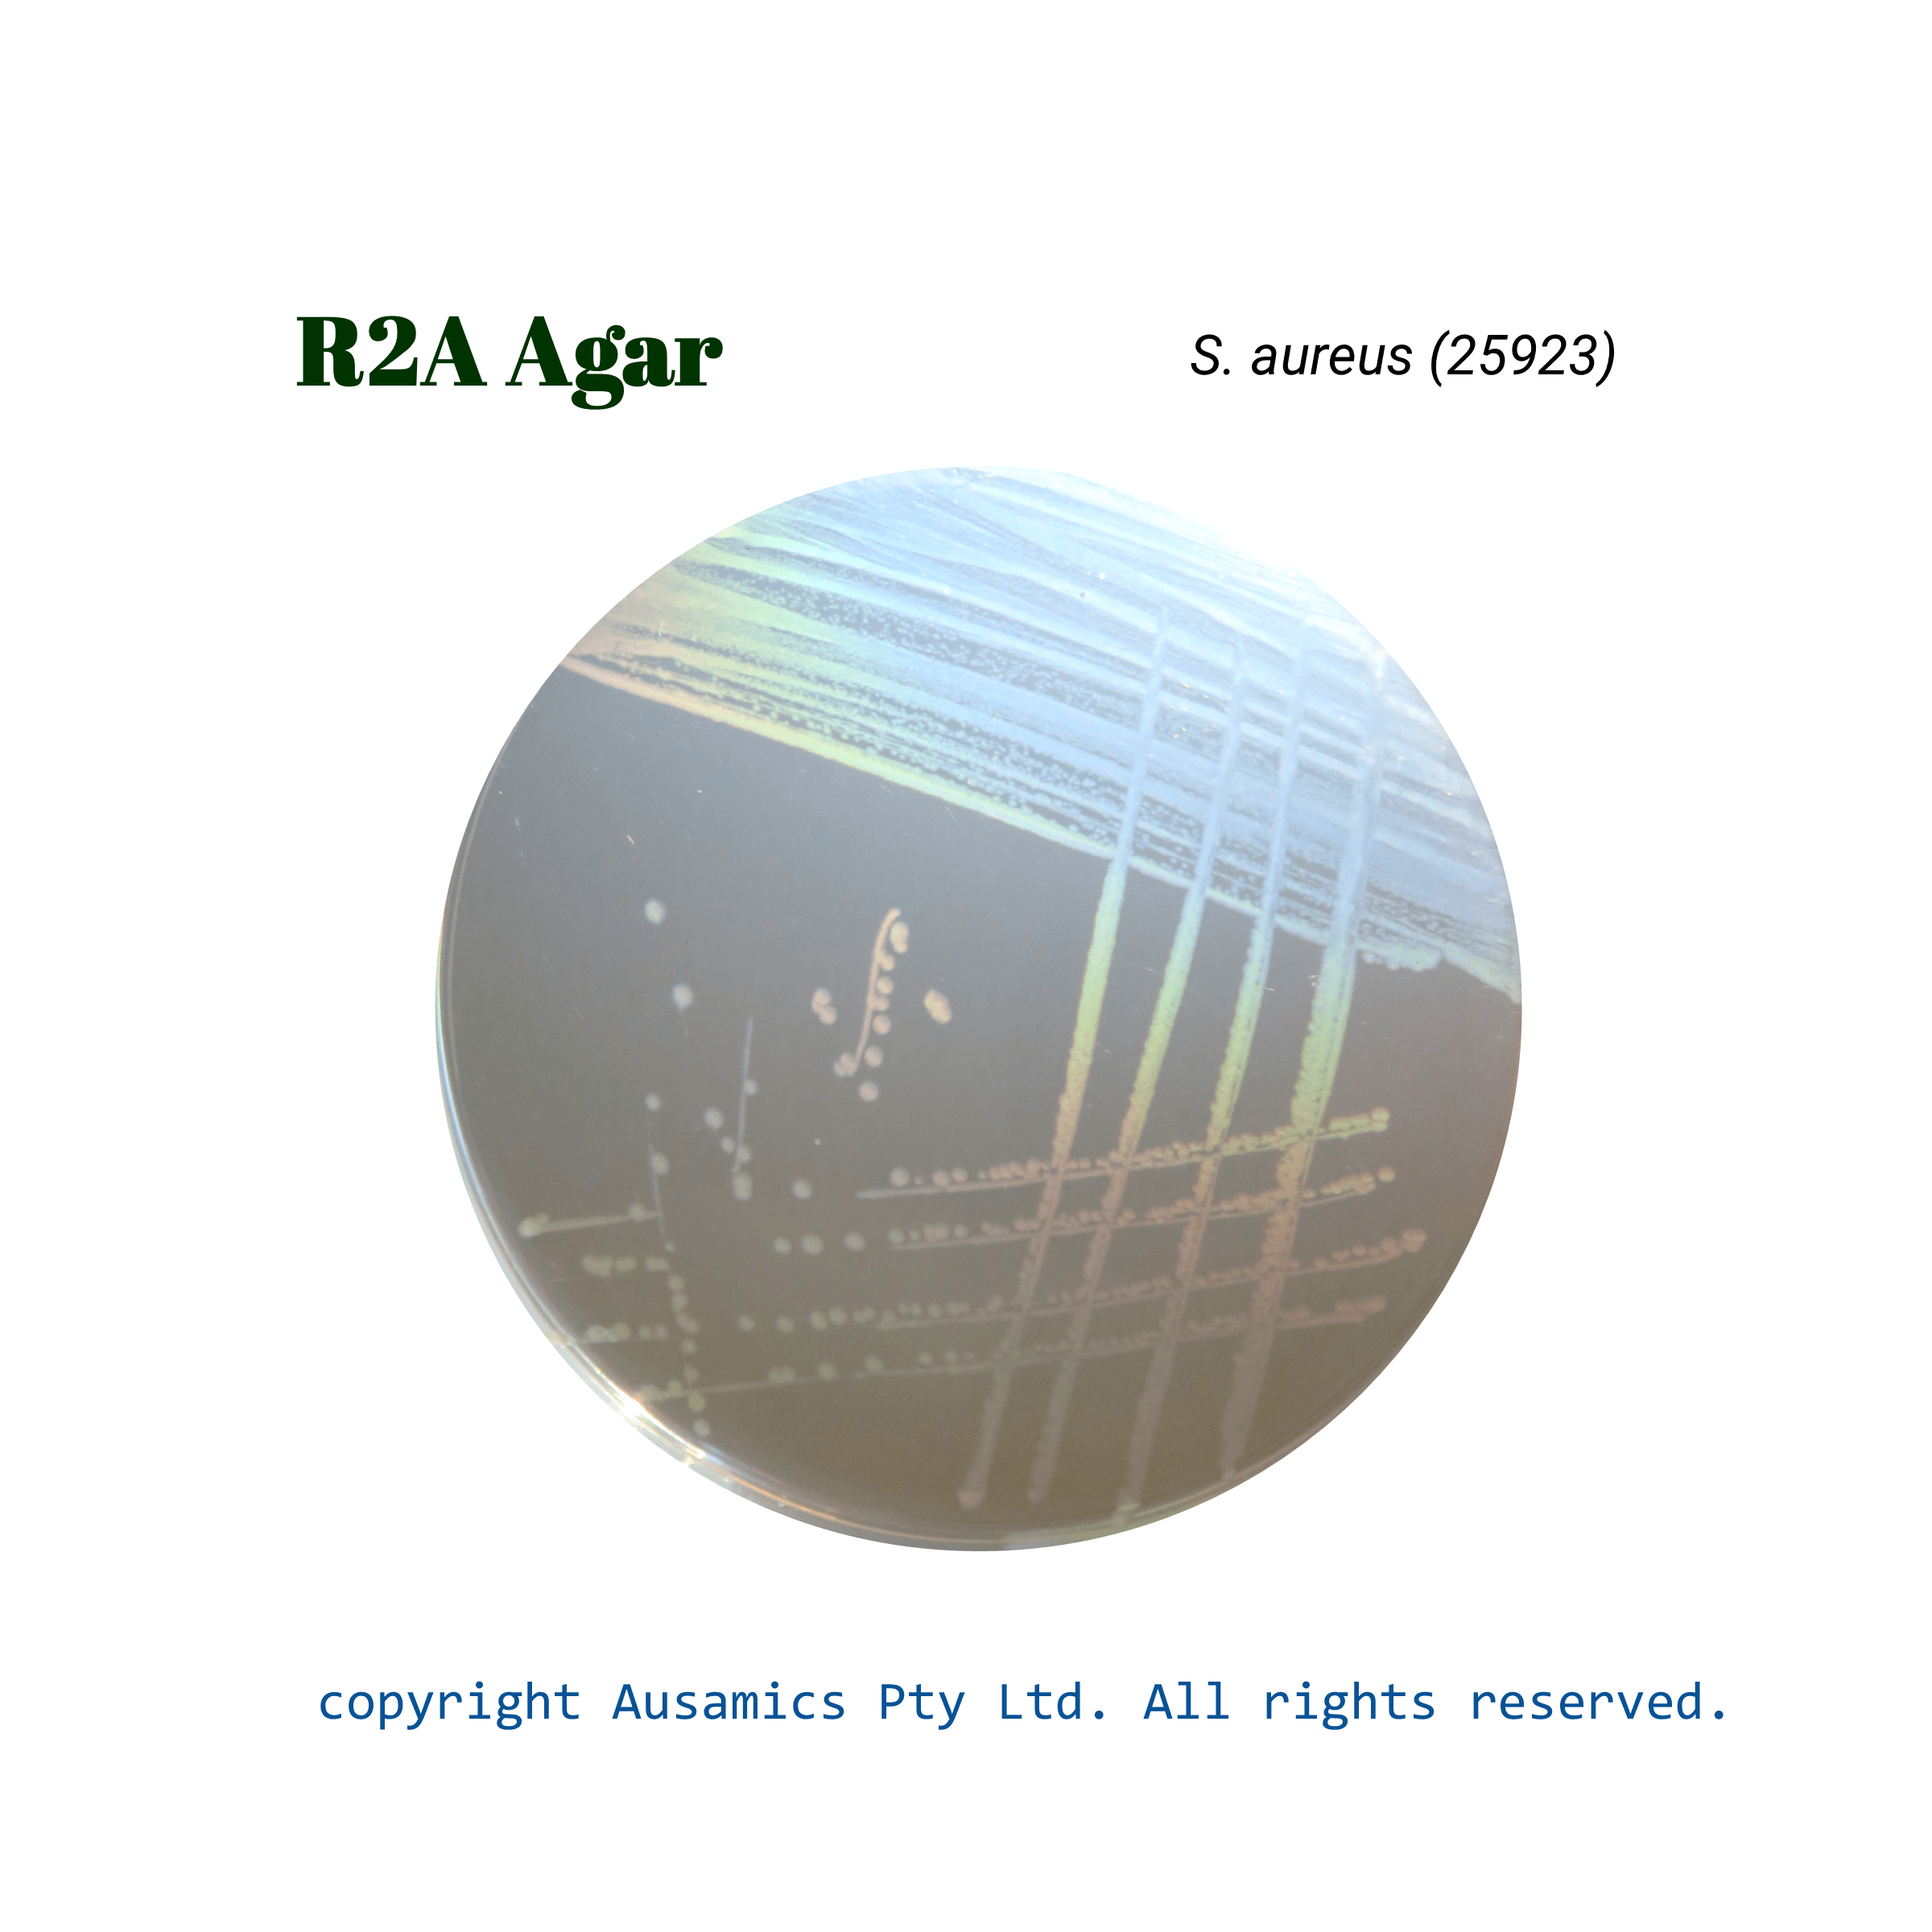
R2A_Agar_Saureus(25923)_Ausamics

R2A Agar
Used in standard methods for pour plate, spread plate, and membrane filter analysis to count heterotrophic bacteria from water samples.
- Description
- Composition
- Quality Control
- Microbial Test Results
R2A Agar is a selective culture medium especially for the counting and isolation of heterotrophic bacteria, especially in the assessment of water quality. It was created by Reasoner and Geldreich with the intention of recovering stressed and chlorine-damaged bacteria that would not be as prevalent in conventional nutrient-rich media. The medium consists of nutrients, including yeast extract, peptones, and glucose, as well as additions such soluble starch, sodium pyruvate, and magnesium sulfate. Compared to conventional medium, R2A Agar increases the range of bacteria that can grow by utilizing longer incubation times and a low-nutrient environment.
This medium is considered as a standard approach for evaluating water quality and is frequently used in many different microbiological procedures, such as membrane filtration, spread plate, and pour plate methods.
Storage
Keep the container at 15-30 °C and prepared medium at 2-8 °C.
| Composition | gr/L |
| Peptones | 1 |
| Yeast Extract | 0.5 |
| Glucose | 0.5 |
| Soluble Starch | 0.5 |
| K2HPO4 | 0.3 |
| Sodium Pyruvate | 0.3 |
| Magnesium Sulphate | 0.05 |
| Agar | 12 |
| Final pH at 25°C | 7.2 ± 0.2 |
| Dehydrated Appearance | Light beige, free-flowing, homogeneous. |
| Prepared Appearance | Light to medium amber, clear to very slightly opalescent. |
| Reaction of 1.52% Solution at 25°C | pH 7.2 ± 0.2 |
| incubate at 35 ± 2 °C for 42 to 48 hours. | |
| Organism (ATCC) | Recovery |
| Enterococcus faecalis (29212) | Good |
| Escherichia coli (25922) | Good |
| Staphylococcus aureus (25923) | Good |
| Pseudomonas aeruginosa (27853) | Good |